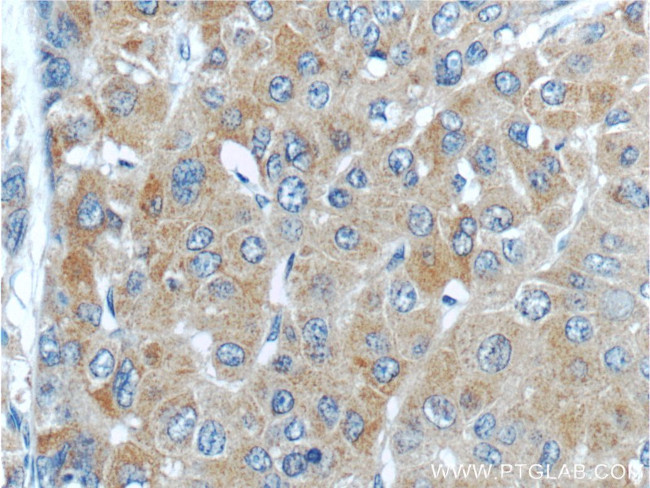
PGLYRP2 Antibody in Immunohistochemistry (Paraffin) (IHC (P))
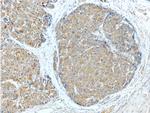
PGLYRP2 Antibody in Immunohistochemistry (Paraffin) (IHC (P))

Search
Proteintech
PGLYRP2 Polyclonal Antibody
{{$productOrderCtrl.translations['antibody.pdp.commerceCard.promotion.promotions']}}
{{$productOrderCtrl.translations['antibody.pdp.commerceCard.promotion.viewpromo']}}
{{$productOrderCtrl.translations['antibody.pdp.commerceCard.promotion.promocode']}}: {{promo.promoCode}} {{promo.promoTitle}} {{promo.promoDescription}}. {{$productOrderCtrl.translations['antibody.pdp.commerceCard.promotion.learnmore']}}
产品信息
23029-1-AP
种属反应
宿主/亚型
分类
类型
抗原
偶联物
形式
浓度
规格
纯化类型
保存液
内含物
保存条件
运输条件
产品详细信息
Immunogen sequence: LLMDSVIQA LAELEQKVPA AKTRHTASAW LMSAPNSGPH NRLYHFLLGA WSLNATELDP CPLSPELLGL TKEVARHDVR EGKEYGVVLA PDGSTVAVEP LLAGLEAGLQ GRRVINLPLD SMAAPWETGD TFPDVVAIAP DVRATSSPGL RDGSPDVTTA DIGANTPDAT KGCPDVQASL PDAKAKSPPT MVDSLLAVTL AGNLGLTFLR GSQTQSHPDL GTEGCWDQLS APRTFTLLDP KASLLTMAFL NGALDGVILG DYLSRTPEPR PSLSHLLSQY YGAGVARDPG FRSNFRRQNG AALTSASILA QQVWGTLVLL QRLEPVHLQL QCMSQEQLAQ VAANAT (25-369 aa encoded by BC136551)
靶标信息
Peptidoglycan recognition proteins, such as PGRPL, are part of the innate immune system and recognize peptidoglycan, a ubiquitous component of bacterial cell walls.
仅用于科研。不用于诊断过程。未经明确授权不得转售。
篇参考文献 (0)
生物信息学
蛋白别名: N-acetylmuramoyl-L-alanine amidase; Peptidoglycan recognition protein 2; peptidoglycan recognition protein L; Peptidoglycan recognition protein long; PGRP-L; unnamed protein product
基因别名: HMFT0141; PGLYRP2; PGLYRPL; PGRP-L; PGRPL; tagL; tagL-alpha; tagl-beta; TAGL-like; UNQ3103/PRO10102
UniProt ID: (Human) Q96PD5
Entrez Gene ID: (Human) 114770